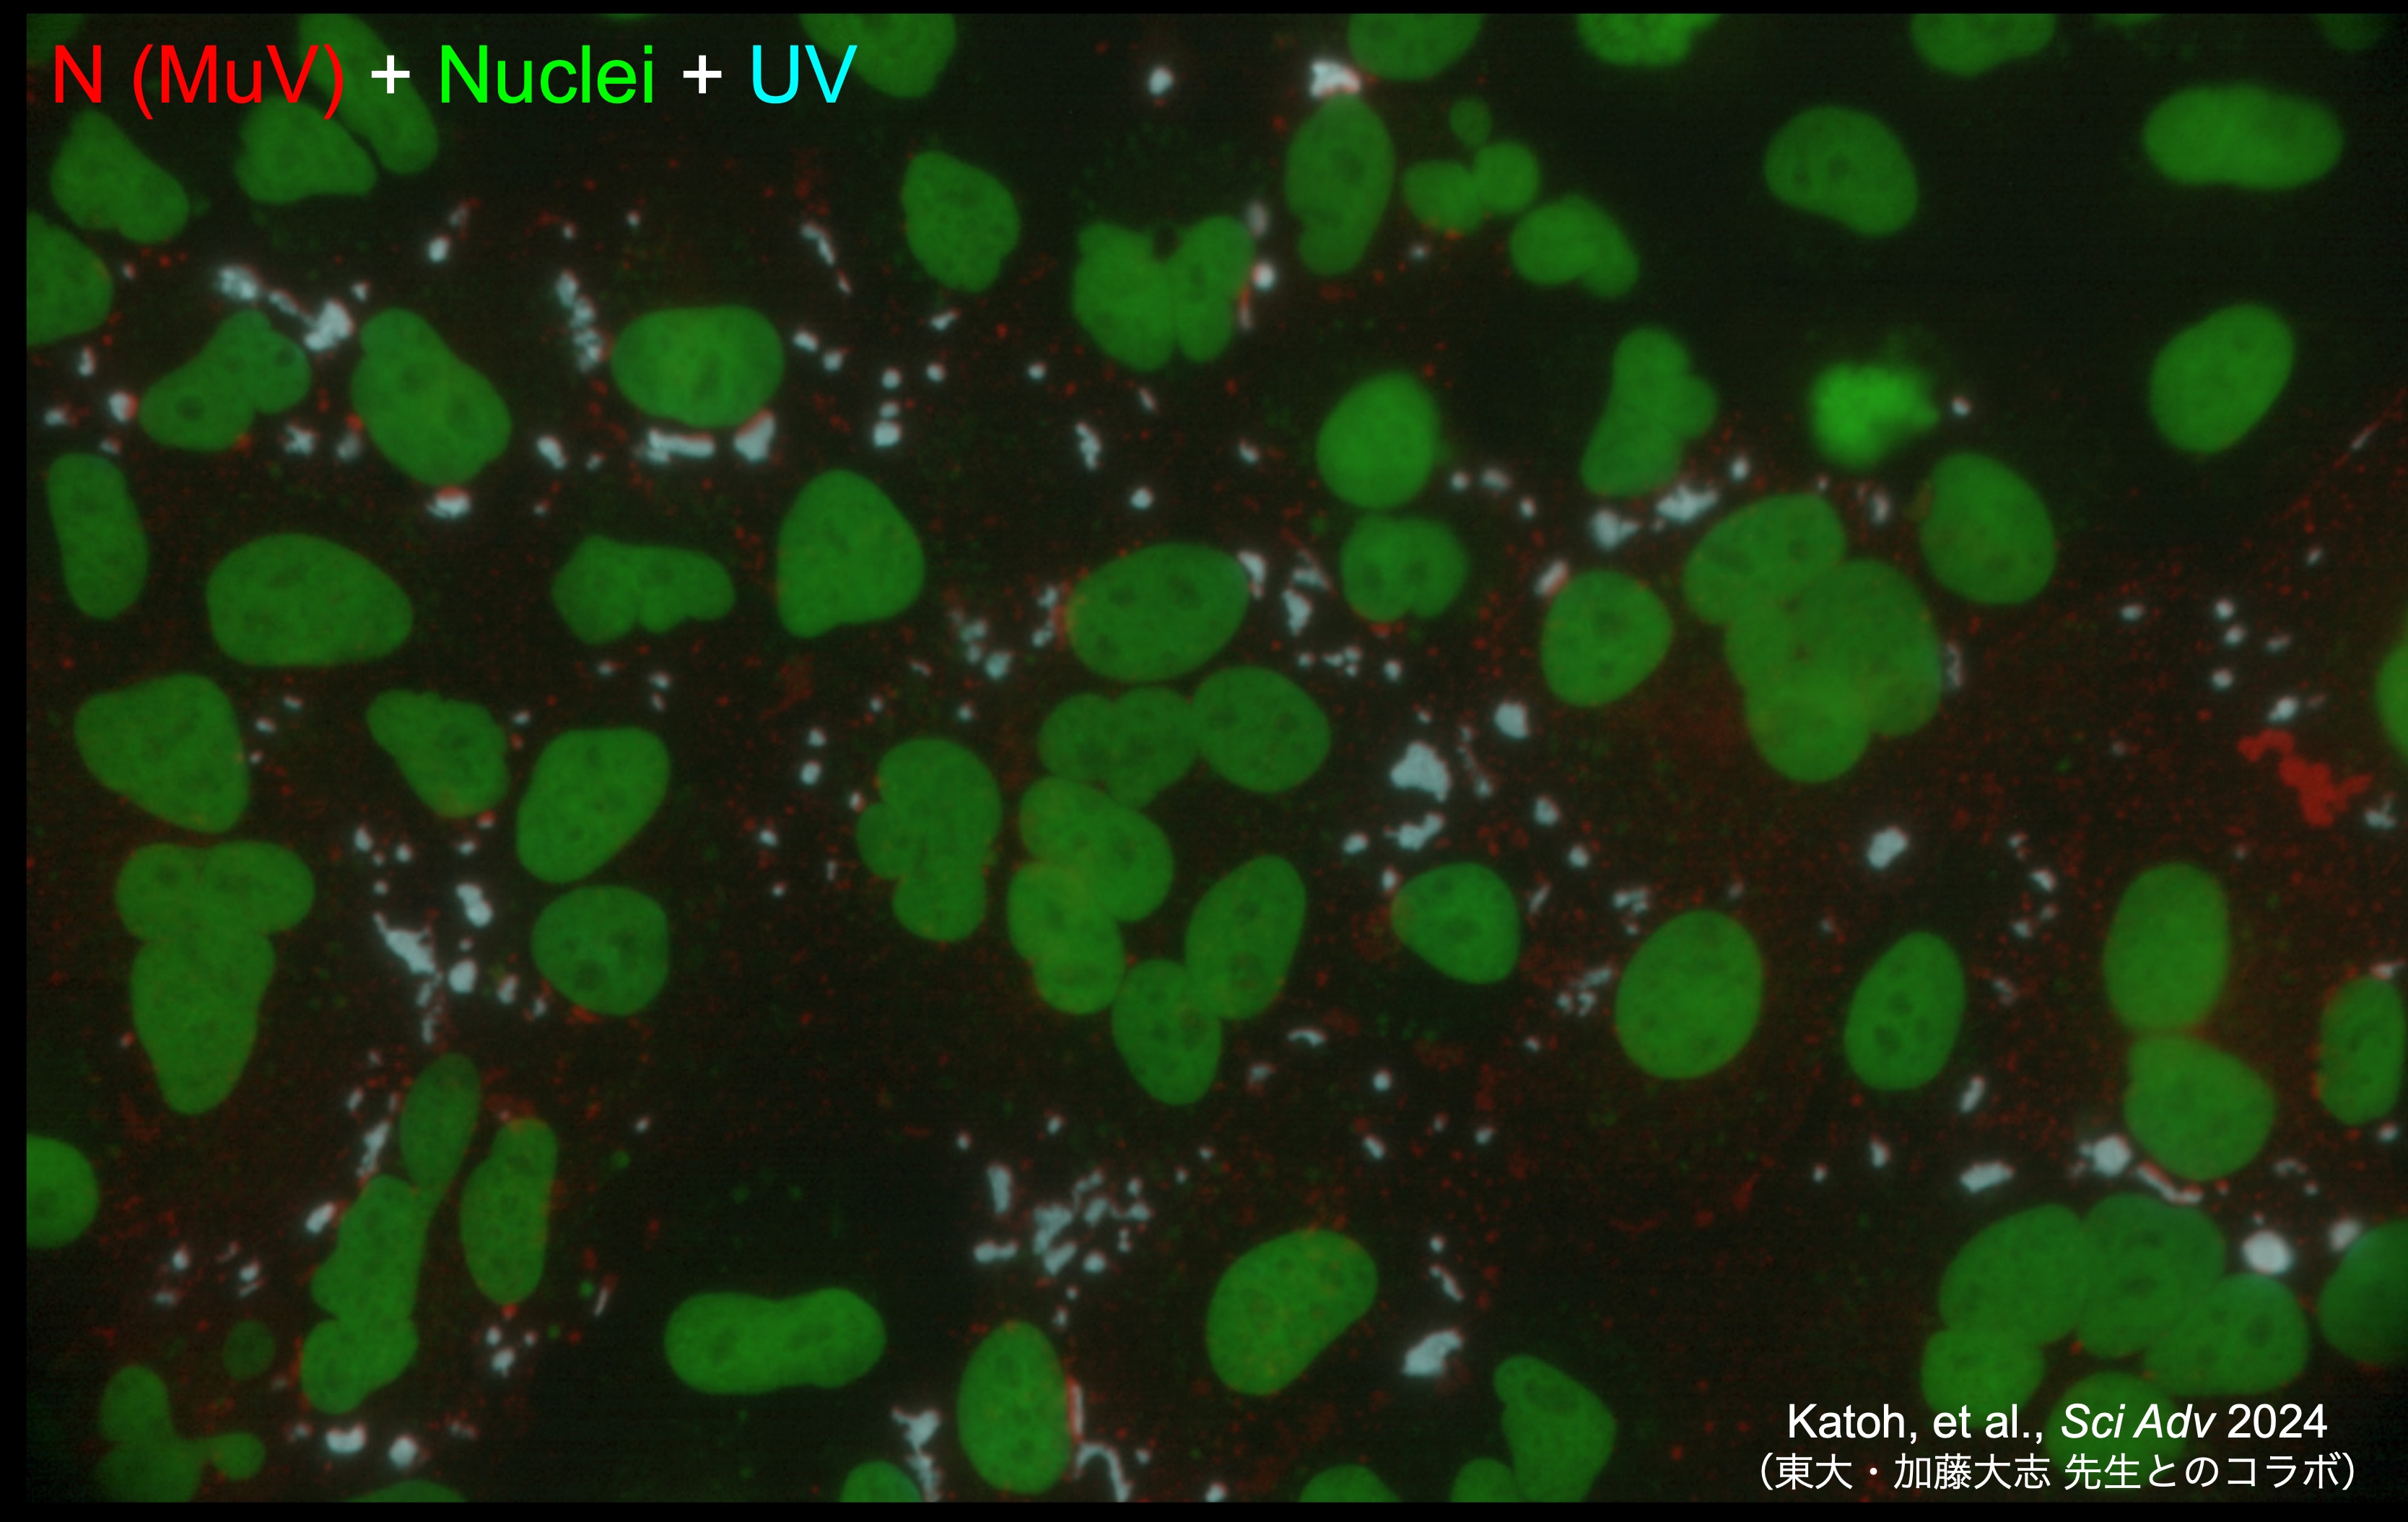

PIC Gallery
2026
Collaboration with Dr. Atsuda (Kyushu Univ) Paper
To compare the emu, which has a flat breastbone, with the chicken, which has a keel and thick breast muscles, we performed PIC RNA sequencing on sternal progenitor cells from the embryos of both species. Our results revealed significant differences in the duration of TGF-β signaling activation between the two species, suggesting that these differences may account for the variation in sternal morphology between species.
Collaboration with Dr. Ohnishi (Kyoto Univ) Paper
We performed PIC RNA-seq on mouse vocal-fold mucosal epithelium and identified stem-cell markers involved in tissue repair.
2025
Collaboration with Dr. Ishitani (Osaka Univ) Paper
We performed PIC RNA-seq on epidermal stem cells of the turquoise killifish, a species known for its extremely short lifespan, revealing age-associated expression changes as well as induction of rejuvenation-related genes after drug treatment.
Collaboration with Dr. Shintani (NCVC) Paper
We performed PIC RNA-seq on stress response marker–positive and –negative cardiomyocytes in mouse myocardium, and revealed reduced expression of genes related to cardiac contraction and cellular respiration under stress response.
2024
Collaboration with Dr. Sawamoto (Nagoya City Univ) Paper
We performed PIC RNA-seq on neuroblasts migrating toward injured regions in the mouse brain and found updating of TGF-beta signaling.
Collaboration with Dr. Katoh (Univ Tokyo) Paper
We performed PIC RNA-seq on inclusion bodies formed during mumps virus infection and found enrichment of RNAs with G4 structures.
名市大・齋藤伸治先生との共同研究 Paper
We performed PIC RNA-seq on brain organoids from a microcephaly model carrying pathogenic variants. By comparing gene expression restricted to the ventricular zone, we found downregulation of genes involved in basal radial glia formation.